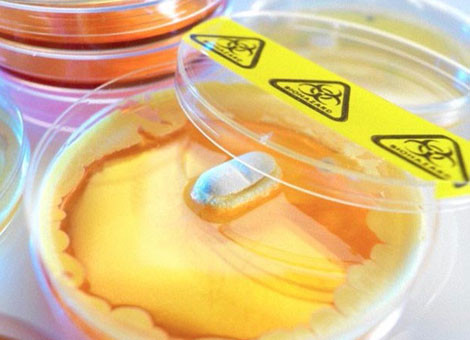
Siêu kháng sinh: Phép màu của y học? ảnh 1

Điều quan trọng là, loại thuốc mới có thể là một vũ khí mạnh trong cuộc chiến chống lại hiện tượng kháng kháng sinh, trong đó, những nhiễm trùng từng dễ chữa trị hiện đã biến đổi thành dạng nguy hiểm chết người sau khi tìm được cách lẩn tránh các loại thuốc mạnh nhất.
Nhiều người bắt đầu nghĩ rằng bệnh tật có thể bị chinh phục. Tuy nhiên, thực tế lại khác xa những gì con người đã và đang kỳ vọng. Ngày nay trong thế kỷ 21, sự xuất hiện của nhiều chủng vi khuẩn kháng thuốc đã gia tăng nguy cơ lây lan các bệnh truyền nhiễm khó chữa và các loại vi khuẩn gây bệnh có điều kiện. Mỗi khi một loại thuốc kháng sinh mới được phát minh ra thì lại xuất hiện một nhóm các chủng loại vi khuẩn kháng thuốc hoàn toàn mới. Câu hỏi được đặt ra là: liệu thuốc kháng sinh có thực sự là “một phép màu” mang đến cho chúng ta khả năng tiêu trừ mọi bệnh tật hay không?
Siêu kháng sinh… từ đất
Theo các chuyên gia, nhiều loại vi khuẩn và nấm tạo ra kháng sinh tự nhiên để giữ chúng an toàn và tiêu diệt đối thủ cạnh tranh thức ăn cũng như không gian. Tuy nhiên, với việc các vi trùng dễ nghiên cứu đã được tìm hiểu kỹ lưỡng và các vi khuẩn còn lại trong đất rất khó nuôi cấy trong phòng thí nghiệm, các nhà khoa học hiện đại gần như bỏ lỡ con đường nghiên cứu trên để theo đuổi các cách tiếp cận vận dụng công nghệ cao nhiều hơn.
Với quan điểm cho rằng, đất còn chứa đựng nhiều bí mật hơn nữa, các nhà nghiên cứu đến từ Đại học Tây Bắc ở Boston (Mỹ) đã sáng chế ra một thiết bị cho phép họ nuôi dưỡng và nghiên cứu vi khuẩn trong đất. Trong số 10.000 loại vi khuẩn nuôi cấy, 25 chất chắt lọc được có tiềm năng sử dụng như thuốc kháng sinh và teixobactin tỏ ra có triển vọng nhất trong đó.
Trong các thử nghiệm, teixobactin giết chết một loạt các vi khuẩn, bao gồm cả MRSA - loại tụ cầu vàng kháng Methicillin, không đáp ứng điều trị với kháng sinh thông thường, thường gây ra những bệnh nhiễm trùng nghiêm trọng và đe dọa sự sống như nhiễm khuẩn huyết, nhiễm khuẩn vết mổ hay viêm phổi. Teixobactin đặc biệt linh hoạt trong việc chống lại các vi khuẩn dạ dày nguy hiểm và các vi trùng gây hại cho tim. Bệnh lao cũng sẽ trở nên dễ dàng kiểm soát hơn, có thể được điều trị bằng một loại thuốc duy nhất chứ không phải sử dụng hỗn hợp nhiều loại thuốc như hiện nay.
Các thử nghiệm tiến hành trong phòng thí nghiệm đã chứng minh teixobactin tiêu diệt được một số vi khuẩn nhanh chóng và chữa khỏi những con chuột được cho nhiễm khuẩn mà không gây ra bất kỳ phản ứng phụ độc hại nào. Các nhà khoa học cũng thừa nhận teixobactin có khả năng ức chế các lypid béo hình thành bức tường được vi khuẩn sử dụng để tạo ra màng tế bào của chúng. Chính bức tường này ngăn chặn sự tấn công của thuốc kháng sinh và điều đó giải thích tại sao sự kháng cự lại teixobactin không diễn ra.
Cuộc nghiên cứu cũng tiết lộ teixobactin nguyên mẫu có cơ chế tự biến đổi để chống lại được sự kháng thuốc của vi khuẩn nguy hại vốn không ngừng biến đổi - một trong những thách thức lớn nhất trong quá trình phát triển thuốc kháng sinh mới. Do vậy, các vi khuẩn rất khó tìm được cách vô hiệu hóa teixobactin. Theo dự đoán, phải mất ít nhất 30 năm, các vi khuẩn may ra mới có thể phát triển được khả năng đề kháng loại thuốc này.
Đột phá mới này có thể “thay đổi cuộc chơi”, hứa hẹn giải quyết cuộc khủng hoảng kháng sinh hiện nay và mở lối tìm kiếm thêm nhiều loại thuốc kháng sinh hiệu quả trong y khoa trong tình hình sự gia tăng kháng thuốc từ một chuỗi các siêu vi khuẩn, từ đó dẫn đến sự lan tràn các dịch bệnh không có khả năng chữa trị trên toàn cầu. Các công ty dược đã bắt tay vào điều chỉnh công thức và hy vọng sẽ bắt đầu thử nghiệm thuốc trên người trong vòng hai năm. Nếu mọi việc suôn sẻ, teixobactin được sử dụng dưới dạng thuốc tiêm sẽ xuất hiện trên thị trường vào năm 2019.
Âm thầm thâm nhập cơ thể
Theo tiến sĩ vi trùng học người Mỹ Martin Blaser, ngày càng có nhiều bằng chứng về việc thuốc kháng sinh khiến con người phát phì. Trong cuốn sách mới xuất bản, ông Blaser cho biết, sau chiến tranh thế giới lần thứ 2, các nhà nghiên cứu nông nghiệp đã tiến hành tìm hiểu xem liệu thuốc kháng sinh streptomycin có thể làm giảm tỉ lệ tử vong ở những con gà nuôi nhốt hay không.
Khi cho những con gà con mới 1 ngày tuổi sử dụng liều cao loại thuốc kháng sinh mới này, họ kinh ngạc phát hiện đã tạo ra một dòng “siêu gà” mới. Những con gà con này không chỉ thoát khỏi những căn bệnh thường tấn công chúng, mà trong 4 tuần chúng còn lớn gấp đôi những cá thể cùng lứa không được dùng streptomycin. Đột phá đã nhanh chóng được ngành công nghiệp chăn nuôi khắp thế giới ứng dụng để tăng năng suất. Tuy nhiên, ngày càng có nhiều bằng chứng cho thấy, thuốc kháng sinh trong thịt mà con người ăn hàng ngày đang “vỗ béo” chính cơ thể họ. Những loại biệt dược này thậm chí có thể là căn nguyên dẫn đến đại dịch béo đang càn quét các nước phát triển.
Một trong những thử nghiệm đầu tiên diễn ra vào năm 1951 từng hé lộ: 10 đứa trẻ sinh non ở Italia, được cho dùng thuốc kháng sinh chlortetracycline hàng ngày, đã nặng cân hơn 8% so với những đứa trẻ không dùng thuốc. Trong cuộc nghiên cứu kéo dài từ năm 1991 - 2006, tiến sĩ Blaser và các cộng sự đã theo dõi tình trạng sức khỏe của 14.500 phụ nữ và trẻ em. Các chuyên gia nhận thấy, những đứa trẻ sử dụng thuốc kháng sinh trong 6 tháng đầu đời cũng béo hơn nhóm còn lại.
Theo ông Blaser, mỗi người là nơi dung chứa một “quần xã vi sinh vật” quy tụ tới hơn 100 ngàn tỉ vi sinh vật “thân thiện” với trọng lượng tổng cộng có thể lên tới 2kg. Thuốc kháng sinh có thể thay đổi sự cân bằng phức tạp của môi trường bên trong cơ thể người này, dẫn đến sự biến đổi cách cơ thể xử lý đường và chất béo, khiến hấp thu nhiều calo hơn. Một nghiên cứu cho thấy: sự gia tăng chứng béo phì nhanh chóng ở Mỹ trong 20 năm qua thực tế bắt nguồn một phần từ việc đông đảo người dân tiếp xúc lâu dài với một lượng nhỏ thuốc kháng sinh đã xâm nhập vào chuỗi thức ăn của họ trong cùng thời gian.
Các chuyên gia nhận định, khi động vật được cho dùng thuốc kháng sinh, một số biệt dược này có thể vẫn tồn tại trong những sản phẩm chế biến từ cơ thể chúng, như thịt, trứng, hay sữa, và đi vào bữa ăn của mỗi hộ gia đình. Chẳng hạn như, thịt và sữa ở Mỹ và châu Âu có thể được phép chứa tới 100 mcg tetracycline (một kháng sinh phổ rộng cũng dùng cho người) trong 1 kg thực phẩm. “Điều này đồng nghĩa, một đứa trẻ uống 2 cốc sữa/ ngày sẽ tiêu thụ khoảng 50 mcg mỗi ngày, hết ngày này sang ngày khác”, ông Blaser lấy ví dụ.
Nhiều thử nghiệm cho thấy teixobactin là loại siêu kháng sinh có khả năng loại bỏ hầu hết các mầm bệnh mà không gây ra phản ứng phụ độc hại nào.
Nhiều thử nghiệm cho thấy teixobactin là loại siêu kháng sinh có khả năng loại bỏ hầu hết các mầm bệnh mà không gây ra phản ứng phụ độc hại nào.
Những biến đổi đáng sợ
Sự tích lũy kháng sinh suốt thời gian dài có thể ảnh hưởng nghiêm trọng đến hệ vi sinh vật bên trong cơ thể con người, dẫn đến những thay đổi có khả năng làm phát sinh bệnh tật, cũng như làm trầm trọng hóa tình trạng trỗi dậy của các chủng vi khuẩn kháng thuốc kháng sinh.
Thực tế cho thấy, nỗ lực tìm kiếm thuốc kháng sinh không thể theo kịp tốc độ phát triển của các chủng vi khuẩn kháng thuốc khi không có loại thuốc kháng sinh mới nào trình làng trong suốt nhiều thập kỷ qua. Do các loại vi khuẩn hiện nay ngày càng khó tiêu diệt hơn, các chuyên gia từng cảnh báo trong tương lai không xa sẽ có một loại vi khuẩn mới kháng tất cả các loại thuốc kháng sinh. Điều đó có nghĩa là việc chữa trị y tế có thể sớm bị kéo giật lùi trở về tình trạng của thế kỷ 19. Nhiều quan điểm thậm chí đã mô tả một “viễn cảnh tận thế” trong đó, chỉ sau vài năm nữa, các phẫu thuật bình thường như thay khớp háng cũng có thể đe dọa tính mạng vì các nhiễm trùng tương đối nhỏ không còn dễ loại bỏ.
Khả năng kháng thuốc vẫn luôn là mối đe dọa cho con người trong một thời gian dài trong lịch sử sử dụng kháng sinh. Một ví dụ là phế cầu khuẩn gây viêm phổi (streptococcus pneumonia). Trước đây, có thể dùng Penicillin, Erythromycin, Sulfanilamide, và các kháng sinh khác để chữa trị căn bệnh do vi khuẩn này gây ra, nhưng hiện tại chúng trở nên gần như “vô đối”. Trong khi đó, khả năng kháng tám loại kháng sinh khác nhau, kể cả Cephalexin và Amoxicillin, của trực khuẩn mủ xanh Pseudomonas aeruginosa đạt tới 100%. Hay khả năng kháng 16 loại kháng sinh khác nhau (kể cả những loại đắt tiền như Cephalexin và Cefotaxime) của vi khuẩn gây viêm phổi Klebsiella pneumoniae từ 51,85% đến 100%.
Tuy vậy, theo ước tính trung bình, để phát minh ra một loại kháng sinh và thử nghiệm thành công trên người cần ít nhất 10 năm. Trong khi đó, sự xuất hiện một chủng vi khuẩn kháng thuốc chỉ mất khoảng hai năm. Trong cuộc chiến với thế giới vi khuẩn, kho vũ khí của con người đang không ngừng gia tăng, thế nhưng giới khoa học vẫn cứ bại trận. Như một giáo sư từng nhận xét: “Vi khuẩn thông minh hơn con người. Có lẽ đó là một trận chiến mà chúng ta không bao giờ có thể giành được thắng lợi”…










